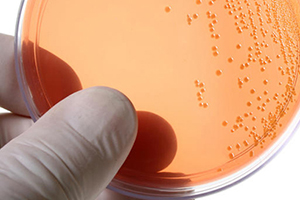

INFEKSIONET DHE PATOLOGJI TE TJERA NE PREPUBERTET (Pjesa e parë)
Te pergjithshme
Infeksionet ne prepubertet nuk jane te rralla, prandaj mjeket qe merren me ekzaminimin e femijeve duhet te jene familjar me keto gjendje klinike. Mjeket duhet te kene informacionin e duhur ne lidhje me shkallen e gjere te variacionit ne pamje te indeve genitale.
Ndryshimet fiziologjike ndodhin nga estrogenet amtare qe cojne ne trashje te mukozes vaginale dhe ne leukorre fiziologjike. Keto ndryshime ndodhin brenda 6 javeve te para te jetes. Si pasoje e uljes se estrogeneve, PH vaginal eshte 6.5-7.5, epiteli behet me i holle, i lemuar dhe atrofik dhe me i ndjeshem ndaj inflamacionit.
Vulvit, vaginit dhe vulvovaginiti jane gjendje inflamatore te traktit te poshtem genital (vulva,vagina). Ato shkaktohen si pasoje e prishjes se raportit midis flores normale dhe flores potencialisht patogene. Faktoret qe favorizojne inflamacionin jane:
- gjendja hipoestrogenike
- pozicioni anatomik, afersia e vagines me rektumin
- mungesa e dhjamit labial dhe qimezimi pubik
- labia minore te vogla
- higjena lokale e varfer
- shperndarja e mikrobeve te infeksioneve respiratore me dore nga femija ne rruget genitale
- perdorimi i lendeve irritante lokalisht
Shenjat dhe simptomat e infeksioneve genitale
1 - Eritema
Eritema eshte nje nga shenjat me te shpeshta te inflamacioneve vaginale. Ajo takohet si ne patologjite e lokalizuara ne traktin genital, ashtu dhe ne patologji te tjera kutane. Me teper preket labia majora dhe minora. Ne patologjite me te shpeshta kutane jane, ekzema, ekzema seboroike, psoriasis. Takohet dhe kur perdoren lende irritante lokale si: banjo me shume shkume, sapuni, shampo, detergjentet e veshjeve te brendshme, veshmbathje te ngushta.
Keto evitohen duke:
- banje vetem me uje te ngrohte te bollshem per 20 minuta vetem nje here ne dite
- perdor te brendshme pambuku dhe jo sintetike
- perdor detergjent hipoalergjik per veshjet e brendshme
- meso femijen per higjenen e rregullt vaginale dhe perineale
Ne infantet me episode te perseritura te vulvitis, duhet te perjashtohet adezioni labial. Ai rezulton nga mungesa e veprimit te estrogeneve ne kete nivel. Kur eshte i gjere shkakton dhe retension urinar. Trajtimi realizohet duke perdorur estrogen lokal. Kremi aplikohet direkt tek adezioni disa here ne dite per 3-4 jave. Kur adezioni zgjidhet vazhdon te perdoret nje lubrifikant si xhel petroleum, per te parandaluar rekurencen. Mund te perdoret dhe trajtim lokal me betametazon, qe jep rezultat te njejte me kremin me estrogen. Ne format qe nuk i pergjigjen trajtimit te mesiperm, qe kane adezion te trashe dhe te gjere behet trajtimi kirurgjikal.
2 - Pruriti
Pruriti eshte nje nga simptomat e inflamacioneve vaginale dhe gjendjeve te lekures si: lichen sclerosus dhe atrofike. Pruriti takohet dhe ne infeksionet e ndryshme parazitare, prandaj behet nje inspektim i feceve, koprokultura dhe merret mjekimi perkates me antiparazitar.
3 - Sekrecionet vaginale
Sekrecionet vaginale takohen ne vulvovaginite ( 85 %), ne abuzimin seksual (5%), trupat e huaj (3%),a dezionin labial (3%), dhe ne shkaqe te tjera (2%). Keto sekrecione ndryshojne ne ngjyre, ne konsistence, ne ere ne baze te llojit te infeksionit.
4 - Gjakrrjedhja
Me gjakrrjedhje shoqerohen gjendje te ndryshme si: trupat e huaj, vaginiti bakterial, lichen sclerosis, condiloma acuminata, ulcerat genitale, prolapsi uretral, abuzimi seksual, traumat aksidentale.
5 - Dhimbjet vaginale
Dhimbjet vaginale takohen ne: infeksionet urinare, infeksionet vaginale, irritimet vaginale, gjendje kutane vulvare....
Anamneza
- Merret informacion nese femija eshte i mesuar vete per nevojat personale apo jo
- Nese jo, percaktohet lloji dhe sa here nderrohet pampersi
- Nese lahet vete percaktohet menyra me vaske, sapun, shampo...
- Percaktohet nese perdor te brendshme pambuku ose sintetike
- Percaktohet menyra e pastrimit pas defekimit
- Shikon dhe vleresohen sekrecionet vaginale, natyra, konsistenca, ngjyra, era
- Percaktohet nese ka kruarje ne regjionin genital dhe anal
- Percaktohet nese ka ekzeme, diarre, rinit alergjik, infeksione respiratore te siperme
- Nese ka risk per trupa te huaj ne vagine
- Percaktohet risku per abuzim seksual ne baze te sjelljes se femijes
Doja Te dija per lythat gjenitale SI ti sheroj?
Dërguar nga klaudia, më 18 Mars 2017 në 11:19
Pershendetje Klaudia!Trajtimi i lythave genital ose kondilomave behet nga nje mjek gjinekolog.Zgjedhja e metodes se trajtimit varet nga forma,madhesia,numri dhe vendndodhja e tyre.Nese nuk paraqitin shqetesime nuk trajtohen.Nese paraqitin shqetesime si djegie,dhimbje,kruarje...behet trajtimi i tyre.Trajtimi behet me medikamente ose me kirurgji.Trajtimi me medikamente behet me kremra ose gel qe aplikohet direkt te lezioni dhe shkakton djegie kimike te tyre si psh me podophyllin kurse trajtimi kirurgjikal zakonisht rezervohet ne lythat e medhenj,ne format rezistente te trajtimit me medikamente apo ne shtatzani.Trajtimi njekohesisht realizohet dhe tek partneri kur paraqet lytha genital.
Përgjigje nga Dr. Ilda Ndreko, më 19 Mars 2017 në 05:31
prsh desha me e nda me ju kam shum shpesh dhimbje ne fund te barkut tek vezet qka mund te jet ju falimnderit
Dërguar nga chendresa Ramadani , më 23 Dhjetor 2022 në 19:22
Pershendetje Chendresa ! Ne radhe te pare duhet bere nje ekografi per te pare mitren dhe vezoret.
Përgjigje nga Dr. Ilda Ndreko, më 24 Dhjetor 2022 në 02:37